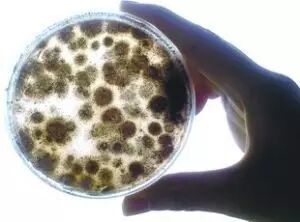

天气回暖,这个地方不清洗将导致车内变成“细菌储藏室”!
随着3月到来,天气开始回暖,气温逐渐升高,汽车空调也慢慢开始从暖风变为冷风输出。但经过一个冬天的沉寂,汽车空调也该清理了。否则对于老人小孩、呼吸道敏感人士来说简直是噩梦。
经过一个冬天的沉淀,汽车空调过滤网积攒了非常多灰尘,并且由于冬季长期使用暖风,容易导致空调内部滋生细菌。当天气开始回暖,将空调调至冷风时会有不少粉尘和细菌飞出,导致空调产生异味,并堵塞出风口,严重降低制冷效果。最恶心的是有些车内空调还有死老鼠、死昆虫等腐烂的东西发臭。

空调内都有些什么?
专家表明,不定期清洗的空调内部滋生大量细菌(主要包括霉菌、大肠埃希氏菌、金黄色葡萄球菌、白假丝酵母菌等)产生怪异的味道,长时间停留在这样的空调环境下,容易让人患上“空调病”。临床主要表现为胸闷、头晕、恶心、乏力、关节痛、食欲下降,记忆力减退、鼻塞、耳鸣等症状,有些还伴有低热、女性可能出现月经不调。还容易感染皮肤病。

▲显微镜下的真菌
▲霉菌

▲金黄色葡萄球菌
...
空调里还有什么?
有时候车主还伴有身上起痒,起红豆豆等症状。这也是空调病的一种,主要是尘螨在作祟。空调系统里的螨虫存在得更广泛,不光在蒸发箱上,而且人家是带腿的生物,有行动能力,这一点比真菌厉害多了,有灰、有营养的地方就少不了它们。

空调内异味及细菌的去除方法:
1、利用风机高档位运行
对于轻微的异味来说,可以将车辆停放在太阳下面,调整旋钮至暖风档,然后将风机开到最高档位,打开所有车门使脏空气排到室外。这样做既可以利用紫外线对车内进行消毒,还可以有效的清理一下风道内的尘土,运行5分钟左右就会有效的去除汽车空调异味。
2、更换空调滤清器
空调滤芯是最容易被忽视的地方,很多车主甚至还不知道汽车上有个空调滤芯,过脏的滤芯不仅起不到原本的作用,还会对进入车内的空气造成二次污染。正常情况下,一个原厂的空调滤芯使用寿命为一年或3万公里,如果车辆经常在空气质量较差的路面行驶,就要适时缩短滤芯的更换周期了。
3、清洗空调风道
更换空调滤芯可以有效阻止一些脏物和细菌进入车内,但如果风道内留有细菌,还会产生异味。使用空调风道清洗剂可以清除风道内的异味。车主可按需选购空调风道清洗剂。清洗的方法也很简单,将车停在空气环境良好的地点后,打开外循环开关将空调开至自然换气挡,然后将清洗剂对准送风口均匀喷入风道,几分钟后,开窗开空调彻底通风即可。当然,这种方法也是适用于污染不很严重的风道,如果是那些长时间未清洗过风道的车辆,最好还是到专业的4S店给车做一次彻底的空调深度清洗护理比较好。
4、清洗蒸发器
空调蒸发器是制冷剂蒸发并对空气进行制冷的重要部件,空气中水蒸汽会在蒸发器上凝结,使蒸发器长期处于潮湿状态,容易滋生霉菌,产生异味。因此,想要根治汽车空调有异味,必须将蒸发箱表面清洗干净,包括通风管道等一些列部件,这样汽车空调异味的问题才可能根治。另外,在冬季每个月至少开启一次冷风,每次开启时间3~5分钟,这样有利于保持蒸发器干燥,减少霉菌生长。
乌海鑫安众诚一汽大众4S店专业建议:
汽车使用半年或者1万公里必须做空调系统保养。
空调系统保养的4大标准:
1、出风口或车内有异味;
2、空调格脏或更换空调格时;
3、汽车蒸发器有污垢或长霉菌;
4、鼓风机有污垢,需要做空调系统保养。
免责声明部分文章来源于互联网及其他公众平台,内容仅供读者参考,不确保文章的准确性,如有侵犯版权请告知,我们将在24小时内删除!

|